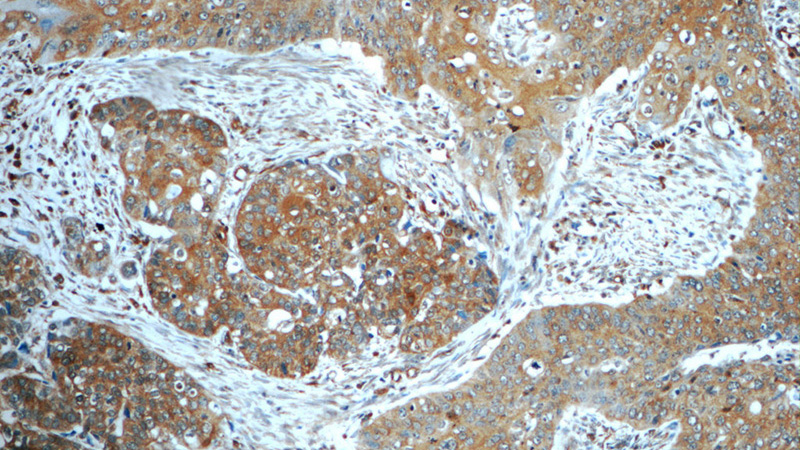
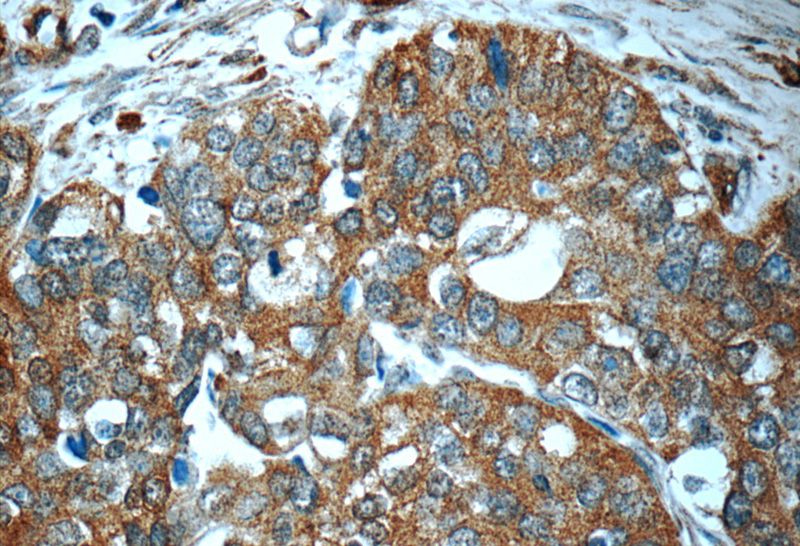

-
Product Name
Interferon gamma antibody
- Documents
-
Description
Interferon gamma Rabbit Polyclonal antibody. Positive IHC detected in human cervical cancer tissue, human heart tissue, human liver tissue, human spleen tissue, human testis tissue. Positive WB detected in Transfected HEK-293 cells, mouse thymus tissue, Recombinant protein.
-
Tested applications
ELISA, IHC, WB
-
Species reactivity
Human, Mouse; other species not tested.
-
Alternative names
IFG antibody; IFI antibody; IFN gamma antibody; IFNG antibody; IFN-γ antibody; Immune interferon antibody; Interferon gamma antibody; interferon antibody; gamma antibody
-
Isotype
Rabbit IgG
-
Preparation
This antibody was obtained by immunization of Interferon gamma recombinant protein (Accession Number: NM_000619). Purification method: Antigen affinity purified.
-
Clonality
Polyclonal
-
Formulation
PBS with 0.02% sodium azide and 50% glycerol pH 7.3.
-
Storage instructions
Store at -20℃. DO NOT ALIQUOT
-
Applications
Recommended Dilution:
WB: 1:200-1:2000
IHC: 1:20-1:200
-
Validations

Recombinant protein were subjected to SDS PAGE followed by western blot with Catalog No:111869(IFNG antibody) at dilution of 1:2000

Transfected HEK-293 cells were subjected to SDS PAGE followed by western blot with Catalog No:111869(IFNG Antibody) at dilution of 1:500
Immunohistochemistry of paraffin-embedded human cervical cancer tissue slide using Catalog No:111869(IFNG Antibody) at dilution of 1:50 (under 10x lens)
Immunohistochemistry of paraffin-embedded human cervical cancer tissue slide using Catalog No:111869(IFNG Antibody) at dilution of 1:50 (under 40x lens)
-
Background
Interferon gamma (IFNG) is a soluble cytokine that is the only member of the type II class of interferons. It is secreted by Th1 cells, cytotoxic T cells and NK cells. The cytokine is associated with antiviral, immunoregulatory and anti-tumor properties and is a potent activator of macrophages. It plays crucial roles in pathogen clearance. Aberrant IFNG expression is associated with a number of autoinflammatory and autoimmune diseases. It has been identified in many studies as a biomarker for pleural tuberculosis (TB). Mutations in this gene are associated with aplastic anemia.
-
References
- Xie S, Ding L, Xiong Z, Zhu S. Implications of Th1 and Th17 cells in pathogenesis of oral lichen planus. Journal of Huazhong University of Science and Technology. Medical sciences = Hua zhong ke ji da xue xue bao. Yi xue Ying De wen ban = Huazhong keji daxue xuebao. Yixue Yingdewen ban. 32(3):451-7. 2012.
- Liu ZK, Wang RC, Han BC, Yang Y, Peng JP. A novel role of IGFBP7 in mouse uterus: regulating uterine receptivity through Th1/Th2 lymphocyte balance and decidualization. PloS one. 7(9):e45224. 2012.
- Wang Q, Ma X, Chen Y. Identification of interferon-γ as a new molecular target of liver X receptor. The Biochemical journal. 459(2):345-54. 2014.
- Ma X, Wang Q, Liu Y. Inhibition of tumor growth by U0126 is associated with induction of interferon-γ production. International journal of cancer. 136(4):771-83. 2015.
- Dill MT, Makowska Z, Duong FH. Interferon-γ-stimulated genes, but not USP18, are expressed in livers of patients with acute hepatitis C. Gastroenterology. 143(3):777-86.e1-6. 2012.
- Chai H, Yang L, Gao L. Decreased percentages of regulatory T cells are necessary to activate Th1-Th17-Th22 responses during acute rejection of the peripheral nerve xenotransplantation in mice. Transplantation. 98(7):729-37. 2014.
- Wang H, Li J, Pu H. Echinococcus granulosus infection reduces airway inflammation of mice likely through enhancing IL-10 and down-regulation of IL-5 and IL-17A. Parasites & vectors. 7:522. 2014.
- Owusu L, Wang B, Du Y, Li W, Xin Y. The quantum of initial transformed cells potentially modulates the type of local inflammation mechanism elicited by surrounding normal epithelial tissues and systemic immune pattern for tumor arrest or progression. Journal of Cancer. 6(2):128-38. 2015.
Related Products / Services
Please note: All products are "FOR RESEARCH USE ONLY AND ARE NOT INTENDED FOR DIAGNOSTIC OR THERAPEUTIC USE"
